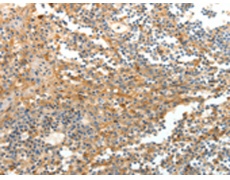
一抗

|
Background: |
Regulator of Notch signaling, a signaling pathway involved in cell-cell communications that regulates a broad spectrum of cell-fate determinations. Probably acts both as a positive and negative regulator of Notch, depending on the developmental and cell context (By similarity). Functions as an ubiquitin ligase protein in vitro, suggesting that it may regulate the Notch pathway via some ubiquitin ligase activity. |
|
Applications: |
ELISA, WB, IHC |
|
Name of antibody: |
DTX3 |
|
Immunogen: |
Fusion protein of human DTX3 |
|
Full name: |
deltex E3 ubiquitin ligase 3 |
|
Synonyms: |
RNF154; deltex3 |
|
SwissProt: |
Q8N9I9 |
|
ELISA Recommended dilution: |
1000-5000 |
|
IHC positive control: |
Human tonsil |
|
IHC Recommend dilution: |
25-100 |
|
WB Predicted band size: |
38 kDa |
|
WB Positive control: |
SKOV3 cells |
|
WB Recommended dilution: |
200-1000 |


 購(gòu)物車
購(gòu)物車 幫助
幫助
 021-54845833/15800441009
021-54845833/15800441009